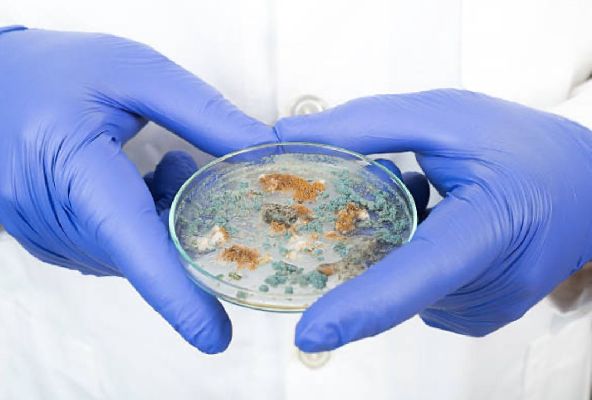

В Москве хозяйка избила собаку в лифте — прокуратура начала проверку

В Москве на Самаркандском бульваре камера видеонаблюдения зафиксировала, как женщина жестоко обращается со своей собакой. Об этом сообщает связанный с силовыми структурами Telegram-канал.
Инцидент произошёл в подъезде многоэтажного дома: питомец не захотел заходить в лифт, и хозяйка в ярости схватила его за шкирку и бросила в кабину.
На этом агрессия не закончилась — всё время, пока лифт поднимался, женщина продолжала пинать животное. Видео быстро распространилось по соцсетям и вызвало волну возмущения.
Неравнодушные соседи, увидев кадры, обратились в полицию и прокуратуру. Надзорное ведомство уже начало проверку по факту жестокого обращения с животным.Читайте также:
 В российском регионе подростки открыли наркомагазин и попались
В российском регионе подростки открыли наркомагазин и попались Сотрудница аптеки украла из кассы более 150 тысяч рублей
Сотрудница аптеки украла из кассы более 150 тысяч рублей Кашель со смертельным диагнозом: у девушки нашли плесень в лёгких после отпуска в Турции
Кашель со смертельным диагнозом: у девушки нашли плесень в лёгких после отпуска в Турции

